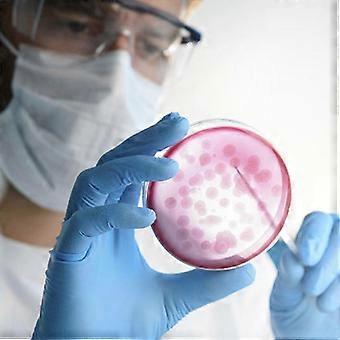
product image

Prepoured Agar Plates in Petri Dishes for Science Experiments (20 Count)
+ NOK 219,49 i frakt

Prepoured Agar Plates in Petri Dishes for Science Experiments (20 Count)
- Merke: Unbranded
Prepoured Agar Plates in Petri Dishes for Science Experiments (20 Count)
- Merke: Unbranded
Spar NOK 370,00 (49%)
Veiledende pris
Spar NOK 370,00 (49%)
Veiledende pris
Vi godtar følgende betalingsmetoder
Beskrivelse
- Merke: Unbranded
- Kategori: Petriskåler
-
Størrelse : 7.00X7.00X1.00CM
- Fruugo-ID: 437831134-917690802
Produktsikkerhetsinformasjon
Vennligst se produktsikkerhetsinformasjonen som er spesifikk for dette produktet skissert nedenfor
Følgende informasjon er gitt av den uavhengige tredjepartsforhandleren som selger dette produktet.
Produktsikkerhetsetiketter

Levering og retur
Sendes i løpet av 2 dager
-
STANDARD: NOK 219,49 - Levering mellom kl tir. 09 desember 2025–fre. 19 desember 2025
Sendes fra Kina.
Vi gjør vårt beste for å sikre at produktene du bestiller, leveres til deg i sin helhet og i samsvar med dine spesifikasjoner. Skulle du likevel motta en ufullstendig bestilling eller andre varer enn dem du bestilte, eller hvis du av en eller annen grunn ikke er fornøyd med bestillingen, kan du returnere bestillingen eller enkeltvarer i bestillingen og motta full refusjon for varene. Se fullstendige retningslinjer for retur
Produktoverholdelsesdetaljer
Vennligst se samsvarsinformasjonen som er spesifikk for dette produktet skissert nedenfor.
Følgende informasjon er gitt av den uavhengige tredjepartsforhandleren som selger dette produktet.
Produsent:
Følgende informasjon skisserer kontaktinformasjonen til produsenten av det aktuelle produktet som selges på Fruugo.
- Yang Gengshu
- Shanghai Tangchi Trading Co., Ltd.
- 5th Floor, No. 277 Huqingping Road, Minhang District, Shanghai
- Shanghai
- CN
- 201615
- vxe32868459@163.com
- 13822016759
Ansvarlig person i EU:
Følgende informasjon skisserer kontaktinformasjonen til den ansvarlige personen i EU. Den ansvarlige personen er den utpekte økonomiske aktøren basert i EU, som er ansvarlig for samsvarsforpliktelsene knyttet til det relevante produktet som selges til EU.
- Van Lavazza
- Y & H S.R.L.
- Via Gravina 21 MT matera,Trani,Puglia
- Trani
- Italy
- 75100
- itlyhsrl@gmail.com
- 0039 3917722149